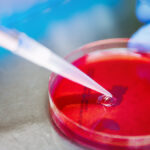

Rzecznik Praw Pacjenta łączy siły z organizacjami pozarządowymi w walce o prawa pacjentów!
2024-04-17
HematoKoalicja o priorytetach refundacyjnych w hematoonkologii
2024-07-08Do grona certyfikowanych ambasadorek projektu „Różowy Patrol powered by Gliss” dołączają Małgorzata Rozenek-Majdan oraz Aleksandra Gawlas-Wilińska z firmy Henkel. Szkolenie, które przeszły uprawnia je do organizowania spotkań i warsztatów promujących profilaktykę raka piersi, w tym również metody samobadania.
Wczesne wykrywanie zmian nowotworowych jest niezwykle istotne, ponieważ gwarantuje wyleczalność nawet w 95% przypadków*. I niezwykle potrzebne z uwagi na bardzo niski, niespełna 30-procentowy**, wskaźnik korzystania z programu badań przesiewowych w Polsce.
W Polsce raka piersi leczy się już na światowym poziomie, zarówno jeśli chodzi o leki, sprzęt, jak i technologie. Jednak kluczem jest tutaj wczesna zgłaszalność na badania, a ta w naszym kraju jest wciąż na niewystarczającym poziomie niespełna 30%. Dla porównania w innych krajach europejskich, takich jak chociażby państwa skandynawskie, zgłaszalność kształtuje się na poziomie 85-95%. Rak piersi nie boli i nie daje objawów, dlatego samoświadomość i samobadanie są tutaj tak bardzo istotne.
Kobiety często zgłaszają się do lekarza już ze zbyt zaawansowanymi nowotworami. W około 30% przypadków nie można zagwarantować pełnej wyleczalności. W kraju, w którym szacuje się, że rocznie diagnozę raka piersi otrzymuje blisko 25 tysięcy osób, wczesna diagnostyka jest kluczowa, a jednak wciąż niewystarczająco realizowana. Powody są różne. Najczęściej to strach, mała świadomość, niewiedza. By można mówić o efektywności programu przesiewowego, to zgłaszalność powinna wynosić ok. 70%, mamy więc jeszcze dużo do zrobienia. Potrzebny jest ogrom działań, w tym lokalnych, bezpośrednich. Dlatego też program Różowy Patrol opiera się na formule „pracy u podstaw”, gdzie istotną rolę odgrywa rozmowa kobiety z kobietą
„Różowy Patrol powered by Gliss” – odpowiedź na wyzwania profilaktyki raka piersi w Polsce
Bezpośredni kontakt to najlepszy sposób na to, aby w przyjaznej, bliskiej i bezpiecznej atmosferze uzyskać wiedzę oraz praktyczne umiejętności związane z odpowiednio wczesnym wykryciem nowotworu i skutecznym działaniem. Badania amerykańskie dowodzą, że bezpośrednia rozmowa pracownika służby zdrowia, również recepcjonistki czy pielęgniarki, z pacjentem na temat roli i wagi takiej diagnostyki ma w 60% wpływ na decyzję o skorzystaniu z takiej możliwości. Na tym bazuje właśnie program ambasadorski „Różowy Patrol powered by Gliss“ - inicjatywa zapoczątkowana przez naszą Fundację oraz markę Gliss. Jej ideą jest, by być blisko kobiety, tworzyć wspólnotę, która daje silne poczucie, że nigdy żadna z nich nie zostanie sama - gdziekolwiek mieszka i kimkolwiek jest. Każda kobieta nauczona samobadania ma szansę, by odpowiednio wcześnie poddać się leczeniu.
Dotychczasowe efekty programu
Od października 2023 do marca 2024 roku uruchomiliśmy 23 kluby „Różowego Patrolu powered by Gliss“. W tym czasie przeszkoliliśmy w obszarze badań i profilaktyki raka piersi oraz wyposażyłyśmy w materiały edukacyjne ponad 140 Ambasadorek Różowego Patrolu. W czasie sześciu miesięcy działań „Różowych Patroli by Gliss” ambasadorki dotarły bezpośrednio do ponad 7 000 kobiet i mężczyzn.
Dzięki marce Gliss, której misją jest motywowanie i dodawanie odwagi innym kobietom, projekt jest kontynuowany w tym roku i to w jeszcze szerszym zakresie. Przede wszystkim zaangażowanie marki umożliwia rozszerzenie działań w projekcie. Dzięki niemu powstają nowe kluby, zapewnione zostają niezbędne środki na ich funkcjonowanie, a także zwiększa się dostęp do informacji na temat profilaktyki raka piersi.
Rozwój projektu i nowe ambasadorki
Projekt rozwija się dynamicznie. W 2024 roku powstało 13 klubów Różowego Patrolu w województwach: lubelskim, śląskim, łódzkim, mazowieckim, świętokrzyskim i zachodniopomorskim. Planowane jest otwarcie również kolejnych, co jeszcze bardziej rozszerzy zasięg projektu. Wyrazem zaangażowania w budowanie wszechstronności inicjatywy i jej dostępności dla kobiet z różnych środowisk jest również dołączenie do Różowego Patrolu w nowej roli certyfikowanych ambasadorek Małgorzaty Rozenek-Majdan oraz Aleksandry Gawlas-Wilińskiej, dyrektorki marketingu firmy Henkel. Dzięki temu inicjatywa zyskuje dodatkowy wymiar i staje się bardziej widoczna także w kręgach biznesowych i show-biznesowych.
Ambasadorki na początku kwietnia br. przeszły szkolenie w naszej Fundacji z zasad prawidłowego samobadania piersi, budowania wiedzy o profilaktyce, a także aspektów psychologicznych, takich jak wsparcie chorych czy osób, które wykryły u siebie zmiany w piersi. Każda ambasadorka dostała swój fantom i materiały edukacyjne, które stanowią bogate źródło informacji. W ten sposób, wyposażone w wiedzę, empatię i praktyczne narzędzia, stają się nie tylko aktywnymi liderkami zmian, ale także realnym wsparciem dla tych, którzy go potrzebują.
- Bardzo cieszę się z praktycznego wymiaru szkolenia. Umiejętność samobadania to podstawa monitoringu zdrowia piersi każdej z nas. Jako ambasadorka, chcę być wsparciem dla innych kobiet, motywować je do dbania o swoje zdrowie i regularnych badań. Niezależnie od tego, czy znamy się osobiście czy nie, poprzez nasze działania możemy wpływać na siebie nawzajem, dbając o nasze zdrowie i dobrostan – powiedziała Małgorzata Rozenek – Majdan.
- Gliss wspiera kobiety w dbaniu o to, co dla nich ważne: nie tylko o piękne włosy, ale również zdrowie. Jesteśmy dumni, że możemy być częścią tak ważnego projektu wczesnej profilaktyki raka piersi, ponieważ ma on potencjał realnej zmiany, tak bardzo potrzebnej w Polsce, co pokazują liczby. To też moje osobiste powołanie. Wierzę, że to kobieta najlepiej może zrozumieć inną kobietę, jej obawy i potrzeby. Dlatego chcę je inspirować do dbania o swoje zdrowie i pomagać w przekazywaniu istotnych informacji - podkreśliła Aleksandra Gawlas-Wilińska, dyrektorka marketingu Henkel Consumer Brands, przedstawicielka marki Gliss.











